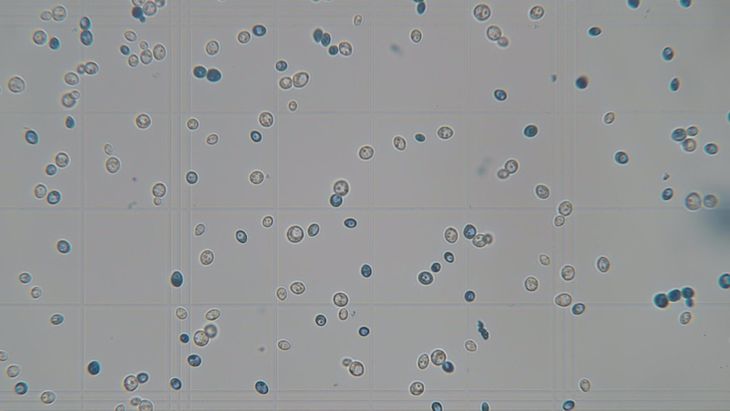
Los hongos son capaces de transformar materias primas en productos finales como pan, cerveza, vino, quesos, chocolate, sake, whisky, miso, kimchi, kéfir, kombucha, entre otros. Foto: gentileza. Los hongos son capaces de transformar materias primas en productos finales como pan, cerveza, vino, quesos, chocolate, sake, whisky, miso, kimchi, kéfir, kombucha, entre otros. Foto: gentileza.

Superalimentos que se producen en la Patagonia
Desde Bariloche, la doctora en Biología Julieta Burini nos invita a descubrir el fascinante mundo de las levaduras y hongos de la Patagonia, y sus tendencias dentro de la industria alimenticia. ¿Son superalimentos?
A finales de abril, se celebró en Bariloche “La Semana del Hongo”, un evento que tiene como objetivo visibilizar y celebrar a los hongos que habitan en la región, conocer sus nombres, principales características, formas, texturas, funciones, propiedades medicinales, sabores, aromas, afectividades y creaciones.
El encuentro reunió a especialistas de diferentes disciplinas, desde biodiversidad, agro y producción, hasta profesionales del arte y documentalistas, con la idea de “informar a la comunidad, abrir el intercambio y debate de todo tipo de información, ciencia, arte, cultura; dar a conocer, visibilizar, hacer llegar a todas las personas la diversidad de hongos que hay, donde habitan, su rol, sus aplicaciones, sus usos”, opinó al respecto la doctora Julieta Burini, panelista del congreso y miembro del grupo de investigación del Centro de Referencia en Levaduras y Tecnología Cervecera (CRELTEC), que pertenece al Instituto Andino Patagónico de Tecnologías Biológicas (IPATEC).
¡Gracias, hongos!
Burini es Licenciada de Ciencia y Tecnología de los Alimentos de la Universidad Nacional de la Plata, y en 2016 armó base en Bariloche para comenzar el doctorado en la Universidad Nacional del Comahue, el cual culminó en 2022. Allí comenzó a trabajar en CRELTEC y su tema de investigación está relacionado con la aplicación de levaduras nativas como herramientas de innovación y diferenciación productiva en el desarrollo de bebidas fermentadas.
“En particular trabajo con la levadura Saccharomyces eubayanus (EUBY®), aislada por primera vez de los bosques patagónicos y que resultó ser uno de los parentales de la levadura Lager (utilizada para producir las cervezas Lager, de mayor consumo a nivel mundial). A lo largo de mi trabajo se logró seleccionar cepas para su aplicación en cerveza, generar los cultivos iniciadores y transferirlos al sector productivo”, contó.
El grupo de investigadores mantienen un lazo de estudio con los productores locales logrando desarrollar cervezas regionales con esta levadura nativa en el marco del Proyecto Patagonia Salvaje. “Actualmente, en mi posdoctorado, evalúo distintas estrategias de aplicación de estas levaduras no convencionales en fábrica, así como su interacción con otros ingredientes de la cerveza, como el lúpulo”, explicó.
“El reino fungi es de mis preferidos. Los hongos me parecen espectaculares, diversos, adaptables, omnipresentes. Cumplen roles fundamentales en los sistemas que habitan. Los hay comestibles y los hay tóxicos”, expresó.
Y agregó: “Estudiarlos implica descubrir este mundo, comprenderlo y cuidarlo, que solo por eso vale la pena. Pero además su estudio también involucra desarrollo y avance. Una de las primeras cosas que nos enseñan es su contribución clave en el ciclo de nutrientes, descomposición de la materia orgánica y formación del suelo”.
“Como humanidad, tenemos que agradecerles desarrollos y avances en áreas de salud (ej. producción de medicamentos, adaptógenos), biotecnología (ej. producción de enzimas, biocombustibles), agricultura (ej, promotor de crecimiento de plantas, biocontrol), alimentos (hongos comestibles y productos obtenidos por acción de los hongos: panificados, quesos, chocolate, salsa de soja, miso, kéfir, kombucha etc)”, señaló. Y por último, pero no menos importante, destacó: “Y entro en lo que me parece su mayor aporte, en particular de las levaduras (hongos unicelulares) que es el de las bebidas alcohólicas: cerveza, vino, sidra, whisky, sake entre muchas otras. ¡Gracias hongos!”.
Rol central en la generación de alimentos
La utilización de hongos, levaduras y fermentos en el ámbito culinario es un procedimiento que los seres humanos utilizamos desde hace siglos para obtener ciertos alimentos muy apreciados: el pan, las bebidas alcohólicas, el queso y otros productos lácteos derivados, como el yogur.
“Los hongos están estrechamente vinculados con la obtención de muchos alimentos y bebidas a través de su metabolismo. Los hongos y levaduras consumen los azúcares, proteínas y lípidos del sustrato donde crecen y producen una gran diversidad de compuestos como: etanol, ácidos orgánicos, ésteres, alcoholes superiores, fenoles, etc”, indicó Burini.
“Así, a través de su acción son capaces de transformar materias primas en productos finales como pan, cerveza, vino, quesos, chocolate, sake, whisky, miso, kimchi, kéfir, kombucha, entre otros. Dependiendo de los microorganismos involucrados (de la/las especie/es de levaduras, o si hay bacterias también) y las condiciones en las que se lleva a cabo la fermentación, se pueden obtener diferentes productos con características únicas de sabor, textura y aroma”, comentó.
En este sentido, la aplicación de los hongos va encontrando su lugar en el mundo y marcando algunas tendencias. La bióloga barilochense, se refirió a que “en el área que yo trabajo, que son las levaduras en la producción de bebidas y alimentos fermentados (en particular hasta ahora trabajamos con cerveza, panificado y whisky), se está investigando la aplicación de levaduras no convencionales como herramientas de innovación y diversificación, e incluso agregado de valor a través del carácter regional”.
Y añadió: “Estas levaduras no convencionales son levaduras distintas a las que se usan tradicionalmente. Las mismas pueden pertenecer al mismo género que las levaduras cerveceras (Saccharomyces), o también a grupos taxonómicos distintos de Saccharomyces. Las primeras involucran levaduras industriales de S. cerevisiae, pero domesticadas para otros procesos fermentativos (como cachaça, sake, etc.), o levaduras no domesticadas de otras especies provenientes de ambientes naturales, consideradas salvajes, como, por ejemplo, S. eubayanus. Las segundas comprenden un amplio grupo de especies con capacidad fermentativa que pertenecen a géneros como Brettanomyces, Torulaspora, Lachancea, Hanseniaspora, Saccharomycodes, Zygosaccharomyces, Pichia, Mrakia, entre otros; aisladas de ambientes naturales, así como de ambientes fermentativos diversos”.
“Otra tendencia actual, es el uso de estas levaduras en la producción de cervezas bajas en alcohol o sin alcohol (NABLAB), así como de cervezas funcionales”, mencionó.
Sello patagónico
De acuerdo a lo que indican los especialistas, la Patagonia tiene una diversidad genética enorme de hongos y tiene un ecosistema propicio para que distintos tipos puedan proliferar. Muchos de ellos son súper alimentos.
En lo que respecta a alimentos y bebidas, tal vez el hongo más popular sea la levadura de la especie Saccharomyces cerevisiae, implicada en la producción de panificados (“la levadura que compramos en el supermercado pertenece a esta especie”, explicó Burisni), y en bebidas alcohólicas como la cerveza, el vino o el whisky. “Es una especie con una relevancia muy grande en esta área”.
Asimismo, la doctora enumeró otras especies de relevancia y recalcó que muchas de ellas se encuentran en la región:
- Saccharomyces pastorianus: “más conocida como levadura Lager, utilizada para producir las cervezas Lager de mayor producción y consumo a nivel mundial; esto se debe a que tiene la capacidad de fermentar a temperaturas bajas. Esta especie es un híbrido entre Saccharomyces cerevisiae y Saccharomyces eubayanus, que como ya dije es una especie nativa que se descubrió por primera vez asociada a los bosques patagónicos y que es la que le otroga al híbrido su capacidad de fermentar en frío”.
- Penicillium roqueforti y Penicillium camemberti: “especies de hongos filamentosos que se utilizan en la producción de quesos como el Roquefort y el Camembert. Contribuyen al desarrollo del sabor, la textura y el aroma característicos de estos quesos”.
-Aspergillus oryzae: “hongo filamentoso que se utiliza en la producción de alimentos fermentados como el miso, el sake y la salsa de soja, otorgándoles sabores únicos”.
- Rhizopus oligosporus: “que se usa en la fermentación del tempeh”
En esta nota